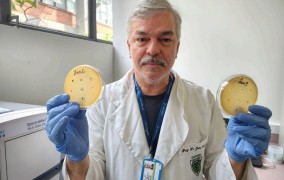

News
-
Technology used to monitor conservation efforts at Rome’s Colosseum will be used at the Ipiranga Museum
2026-06-05The project, which was presented during FAPESP Week London, will use 3D laser scanning to create a digital model of the renovated building and establish an information management system for preventive maintenance. -
Smartwatch detects anxiety and stress in real time
2026-06-05The experimental technology, developed at an Applied Research Center at the State University of Campinas, is already accurate in over 80% of analyses. The research was presented during FAPESP Week London. -
FAPESP and the United Kingdom launch new phase of scientific cooperation in London
2026-06-05At the opening of FAPESP Week, participants celebrated the impact of bilateral cooperation and highlighted artificial intelligence and biotechnology as priority areas for the future. -
Brazil must overcome environmental and technological obstacles to make rare earth mining viable
2026-06-05During FAPESP Week London, expert Fernando Landgraf pointed out that, beyond its mineral potential, the country must master the stages of refining and producing inputs that are globally contested by the United States and China. -
Brazilian nanotechnology enables precise treatment of skin diseases
2026-06-05A research group at the University of São Paulo is producing liquid crystal nanoparticles containing therapeutic molecules that reduce inflammation in diseases such as psoriasis and vitiligo. The advances were presented at FAPESP Week London. -
Study reveals 45 new toxins produced by bacteria associated with foodborne infections
2026-06-03Computational tools were used to analyze the genetic material of 6,165 samples from 149 different types of Salmonella enterica subspecies -
Researchers seek solutions to prevent mental health breakdowns among elementary school teachers
2026-06-03An international seminar organized by the Science Center for the Development of Basic Education brought together experts from eight countries. -
New species of moths described in honor of Orixás
2026-06-03Found in the Amazon, Pantanal, and Atlantic Forest, they were distinguished from what was previously known as a single species by integrating morphological analyses, molecular data, and interactions with host plants. -
New center supported by FAPESP aims to make cities more resilient to flooding
2026-06-03The Flood-Resilient Cities SCD, inaugurated at the Institute for Technological Research, will bring together government, universities, and companies to find solutions to the problem. -
Biomaterial made from jackfruit latex is a promising treatment for periodontitis
2026-06-03With pomegranate peel extract and simvastatin, the product proved effective in combating the infection, inflammation, and periodontal tissue loss caused by the disease. -
FAPESP seeks to boost scientific collaboration between São Paulo and the United Kingdom
2026-06-03The Foundation is promoting the FAPESP Week symposium in England for the third time, with the aim of consolidating and expanding partnerships in strategic areas such as energy transition and artificial intelligence. -
Book addresses soil health in tropical ecosystems
2026-06-03Work supported by FAPESP is the result of an initiative by the Brazilian Soil Health Partnership, the Center for Carbon Research in Tropical Agriculture, and the Luiz de Queiroz Agricultural Studies Foundation. -
Study shows that mutations in the TP53 gene affect the response to lung cancer treatment
2026-06-01The research analyzed tumor samples from over a thousand patients treated in Brazil’s national public health system. -
The temperature in the city of São Paulo has risen more than the global average
2026-05-27The replacement of vegetation with materials such as asphalt, concrete, and masonry exacerbates warming, says a researcher from the University of São Paulo at an event organized by FAPESP and the NWO. -
Study explains why the most massive galaxies in the early Universe stopped forming stars prematurely
2026-05-27Model points to galaxy mergers as the cause of intense bursts of star formation and the formation of supermassive black holes, asserting that active galactic nuclei blocked the supply of raw material for new stars. -
Longer droughts and changes in rainfall are already occurring in the Amazon, research indicates
2026-05-27Recently published studies led by Brazilian scientists indicate an extension of the dry season from four to six months and an increase in the water deficit of more than 150 millimeters. These studies serve as a warning for 2026 and 2027, when a “super El Niño” is forecast. -
Study clarifies conditions for amphibian species richness on marine islands
2026-05-27Analysis of data from over 5,000 territories and 1,924 species of toads and frogs shows that two of the main theories about the biodiversity of plants, birds, and mammals in these habitats do not explain the richness of anuran amphibians on their own. -
Researchers map initiatives in the Amazon that inspire the future of innovation
2026-05-27A scientific mission to the region by a FAPESP-supported RIDC shows how integrating deep tech with local knowledge can help regenerate ecosystems and produce global solutions. -
Fat and muscle mass help prolong the life of patients with head and neck cancer
2026-05-27Two unprecedented studies indicate that early nutritional monitoring can directly impact patient survival. -
Registration is now open for the São Paulo School of Advanced Science in FoodOmics
2026-05-20The event, organized by the State University of Campinas, aims to promote understanding of the potential of omics technologies in science, engineering, food technology, and nutrition. -
Extreme weather events threaten river ecosystems
2026-05-20Research indicates that rivers in different regions of the planet are undergoing profound transformations that exceed their capacity for resilience. -
Scientists discover how a father’s obesity affects his children’s metabolism
2026-05-20Experiments with rodents show that metabolic dysfunction is “transmitted” to offspring through molecules present in sperm, causing them to become pre-diabetic. This phenomenon is reversible through weight loss before conception. -
The duration of depression may influence how severely the disease alters the brain
2026-05-20Researchers from the universities of São Paulo and Oxford show that the duration of the disorder and severity of symptoms are associated with differences in functional brain connections, which may pave the way for personalized treatments. -
Research outlines strategy to protect Amazonian cocoa against witches’ broom
2026-05-20The study identified cultivars that maintain high productivity and resilience against attacks from the disease, paving the way for more sustainable cultivation in the region -
South American Indigenous peoples are diverse and descend from a third wave of migration
2026-05-20A FAPESP-funded study using whole-genome data from across the continent tells a more detailed story of its settlement. The study was featured on the cover of Nature. -
Sabiá virus has been circulating in Brazil for 142 years and mutating, study finds
2026-05-20Researchers at a FAPESP-supported center developed a new method and identified the infection in two patients who died from acute hemorrhagic and neurological syndrome in São Paulo in 2019 and 2020. -
RCGI launches carbon credit registry with scientific rigor
2026-05-20Initiative combines validation with a mandatory fund that transforms credits into investments for science and society. -
Creatine improves physical performance but does not necessarily reduce inflammation
2026-05-18Despite its popularity, researchers at São Paulo State University found no significant effects on inflammatory markers in the body after reviewing studies on the supplement. -
Sustainable electrosynthesis enables production of amines directly from airborne nitrogen
2026-05-13Research conducted by a FAPESP-supported center paves the way for producing chemical inputs widely used in industry, such as in medicines and cosmetics, where they act as active ingredients or stabilizers. -
Basic education is making progress, but structural inequalities pose barriers, says Ivan Siqueira
2026-05-13The assessment was made by the professor from the Federal University of Bahia during the 2nd FAPESP 2026 Conference. He also discussed the limitations of the current model, the need for objective criteria in educational policies, and the impact of artificial intelligence on teaching. -
Even at low concentrations in the air, particulate matter increases hospitalizations for kidney disease
2026-05-13In ten years, levels of this type of pollution in São Paulo, Brazil, reached more than four times the limit recommended by the World Health Organization. -
Biodegradable sensors attached to plants detect pesticides in three minutes
2026-05-13Made from non-toxic plant-based material, the devices can also monitor biomarkers, diseases, and nutrient levels in plants. -
Method calculates more efficient route between Earth and Moon than any previously described
2026-05-13FAPESP-supported research simulated 30 million different routes and mapped out an itinerary requiring 58.80 meters per second less fuel consumption than the most economical one. -
Brazilian technology helps NASA assess health risks for astronauts on mission to the Moon
2026-05-13The U.S. space agency used a device developed by a startup supported by FAPESP to monitor the sleep patterns, physical activity, and interactions of astronauts on the Artemis 2 mission. -
Platform brings together remote sensing images of favelas
2026-05-13Brazil Data Cube-Favelas, a partnership between the National Institute for Space Research and CEFAVELA, a FAPESP RIDC, will provide access to large volumes of data. An article on the technology won an award at the Applied Computing Workshop. -
Microfossils interpreted as animal traces were actually algae and bacteria
2026-05-11New evidence and a reanalysis of 540-million-year-old material using advanced imaging techniques rule out the idea they were from worms or small oceanic animals. -
Genes linked to neuronal communication appear altered in immune cells of patients with depression
2026-05-11Genetic mapping reinforces the systemic nature of the disease and paves the way for developing blood tests that can detect it. -
A body of work that remains fundamental to understanding societies
2026-05-08The Argentine geographer who was a close collaborator of Milton Santos explains how the theory of the two circuits of the urban economy helps interpret current phenomena, such as financialization, digitalization, and the platform economy. -
The dismantling of a false narrative of inevitable progress
2026-05-08In his most celebrated work, Milton Santos deconstructs the myth of universal integration and reveals, in the cracks of the system, the foundations for a globalization grounded in solidarity. -
‘Milton Santos helped transform geography into a social science’
2026-05-08The coordinator of the Milton Santos Archive at USP’s Institute of Brazilian Studies analyzes the geographer’s life’s work and explains how Santos turned territory into a key element of social dynamics. -
A key for understanding underdevelopment
2026-05-08By breaking with European models of urbanization, Milton Santos’s classic work reveals how selectivity and fragmentation shape the territories of countries in the Global South. -
The making of an intellectual educated for the world
2026-05-08From his childhood in hinterland Bahia state to global recognition, Milton Santos’s life reveals a mindset forged through academic rigor and defiance in the face of racism and the transformative experience of exile. -
New long-necked dinosaur found in Northeast Brazil was a close relative of a European species
2026-05-06Dasosaurus tocantinensis was about 20 meters long and lived approximately 120 million years ago. Its closest relative lived in present-day Spain. -
Scientists use ultrasound to destroy influenza A and COVID-19 viruses without damaging human cells
2026-05-06The use of high-frequency waves paves the way for new treatments against other viral infections such as dengue, Zika, and Chikungunya. -
Brazilians obtain Latin America’s first cloned pig for xenotransplantation
2026-05-06Project conducted at the University of São Paulo with support from FAPESP aims to ensure that the country has its own technology and does not depend on imports to perform xenotransplants in the public healthcare system. -
In an experiment, yellow trout grew larger than the wild strain
2026-05-06The performance of the phenotype resulting from a cross with an albino strain was superior to what is typically found in temperate-climate farms of the species, paving the way for the development of new fishery products. -
Online tool helps detect depression and other disorders
2026-05-06Calculator based on the Short Mood and Feelings Questionnaire was developed by researchers at CISM, an Applied Research Center supported by FAPESP. -
Inexpensive material compresses light, paving the way for photonic microcircuits in the terahertz range
2026-05-04Study shows that lead iodide can support phonon-polaritons, allowing radiation to be confined on a nanoscale and enabling new data transmission devices. -
Atmospheric systems control the transport of rainfall and nutrient from Africa to the Amazon
2026-05-04Study indicates that events such as cold air masses in the Northern Hemisphere alter the transport of aerosols across the Atlantic that nourish forest soils. It was previously believed that this influence came from changes in wind direction. -
Small dose of antibiotic yields good results in treating panic attacks
2026-04-29A study involving animals and humans showed that minocycline, in doses lower than those administered for bacterial infections, has an anti-inflammatory effect on microglia, which are brain cells that become more inflamed in people with the disorder.
Most popular
-
Scientists use ultrasound to destroy influenza A and COVID-19 viruses without damaging human cells
2026-05-06
-
Parents’ alcohol and drug use influences their children’s consumption, research shows
2026-02-13
-
Small dose of antibiotic yields good results in treating panic attacks
2026-04-29
-
Longer droughts and changes in rainfall are already occurring in the Amazon, research indicates
2026-05-27
-
Method calculates more efficient route between Earth and Moon than any previously described
2026-05-13
-
Study warns of nutritional risks of prolonged use of the drug omeprazole
2026-02-04
-
Brazilian technology helps NASA assess health risks for astronauts on mission to the Moon
2026-05-13
-
Brazilians obtain Latin America’s first cloned pig for xenotransplantation
2026-05-06
-
Study confirms effectiveness of medicinal plant against SARS-CoV-2 virus
2026-04-29
-
Vitamin D deficiency increases the risk of slow walking speed in old age by 22%
2026-01-21